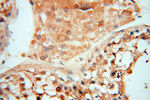
TERF1 Antibody in Immunohistochemistry (Paraffin) (IHC (P))

Search
Proteintech
TERF1 Polyclonal Antibody
{{$productOrderCtrl.translations['antibody.pdp.commerceCard.promotion.promotions']}}
{{$productOrderCtrl.translations['antibody.pdp.commerceCard.promotion.viewpromo']}}
{{$productOrderCtrl.translations['antibody.pdp.commerceCard.promotion.promocode']}}: {{promo.promoCode}} {{promo.promoTitle}} {{promo.promoDescription}}. {{$productOrderCtrl.translations['antibody.pdp.commerceCard.promotion.learnmore']}}
产品信息
11899-1-AP
种属反应
宿主/亚型
分类
类型
抗原
偶联物
形式
浓度
规格
纯化类型
保存液
内含物
保存条件
运输条件
产品详细信息
Immunogen sequence: CQLRTIYIC QFLTRIAAGK TLDAQFENDE RITPLESALM IWGSIEKEHD KLHEEIQNLI KIQAIAVCME NGNFKEAEEV FERIFGDPNS HMPFKSKLLM IISQKDTFHS FFQHFSYNHM MEKIKSYVNY VLSEKSSTFL MKAAAKVVES KRTRTITSQD KPSGNDVEME TEANLDTRKR SHKNLFLSKL QHGTQQQDLN KKERRVGTPQ STKKKKESRR ATESRIPVSK SQPVTPEKHR ARKRQAWLWE EDKNLRSGVR KYGEGNWSKI LLHYKFNNRT SVMLKDRWRT MKKLKLISSD SED (118-419 aa encoded by BC029378)
靶标信息
This gene encodes a telomere specific protein which is a component of the telomere nucleoprotein complex. This protein is present at telomeres throughout the cell cycle and functions as an inhibitor of telomerase, acting in cis to limit the elongation of individual chromosome ends. The protein structure contains a C-terminal Myb motif, a dimerization domain near its N-terminus and an acidic N-terminus. Two transcripts of this gene are alternatively spliced products.
仅用于科研。不用于诊断过程。未经明确授权不得转售。
生物信息学
蛋白别名: alternatively spliced; telomeric protein; FLJ41416; NIMA-interacting protein 2; Telomeric protein Pin2/TRF1; telomeric repeat binding factor (NIMA-interacting) 1; Telomeric repeat-binding factor 1; TTAGGG repeat-binding factor 1; unnamed protein product
基因别名: hTRF1-AS; PIN2; t-TRF1; TERF1; TRBF1; TRF; TRF1
UniProt ID: (Human) A7XP29
Entrez Gene ID: (Human) 7013